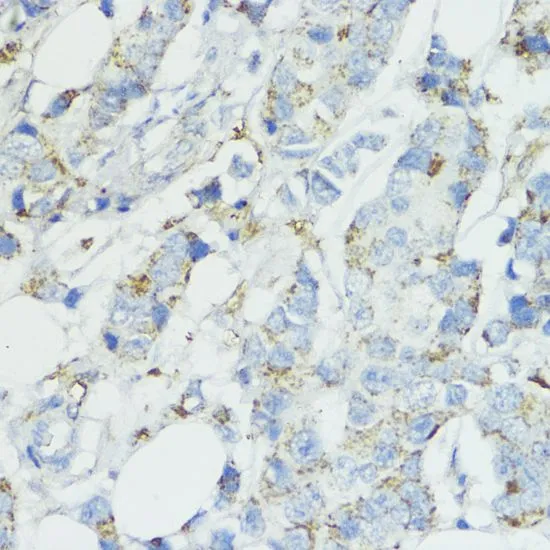

IHC-P analysis of rat ovary tissue using GTX66490 SOD3 antibody. Dilution : 1:100
SOD3 antibody
GTX66490
ApplicationsWestern Blot, ImmunoHistoChemistry, ImmunoHistoChemistry Paraffin
Product group Antibodies
ReactivityHuman, Mouse, Rat
TargetSOD3
Overview
- SupplierGeneTex
- Product NameSOD3 antibody
- Delivery Days Customer9
- Application Supplier NoteWB: 1:500 - 1:2000. IHC-P: 1:50 - 1:200. *Optimal dilutions/concentrations should be determined by the researcher.Not tested in other applications.
- ApplicationsWestern Blot, ImmunoHistoChemistry, ImmunoHistoChemistry Paraffin
- CertificationResearch Use Only
- ClonalityPolyclonal
- ConjugateUnconjugated
- Gene ID6649
- Target nameSOD3
- Target descriptionsuperoxide dismutase 3
- Target synonymsEC-SOD, extracellular superoxide dismutase [Cu-Zn], superoxide dismutase 3, extracellular, testicular tissue protein Li 175
- HostRabbit
- IsotypeIgG
- Protein IDP08294
- Protein NameExtracellular superoxide dismutase [Cu-Zn]
- Scientific DescriptionThis gene encodes a member of the superoxide dismutase (SOD) protein family. SODs are antioxidant enzymes that catalyze the conversion of superoxide radicals into hydrogen peroxide and oxygen, which may protect the brain, lungs, and other tissues from oxidative stress. Proteolytic processing of the encoded protein results in the formation of two distinct homotetramers that differ in their ability to interact with the extracellular matrix (ECM). Homotetramers consisting of the intact protein, or type C subunit, exhibit high affinity for heparin and are anchored to the ECM. Homotetramers consisting of a proteolytically cleaved form of the protein, or type A subunit, exhibit low affinity for heparin and do not interact with the ECM. A mutation in this gene may be associated with increased heart disease risk. [provided by RefSeq, Oct 2015]
- ReactivityHuman, Mouse, Rat
- Storage Instruction-20°C or -80°C,2°C to 8°C
- UNSPSC41116161